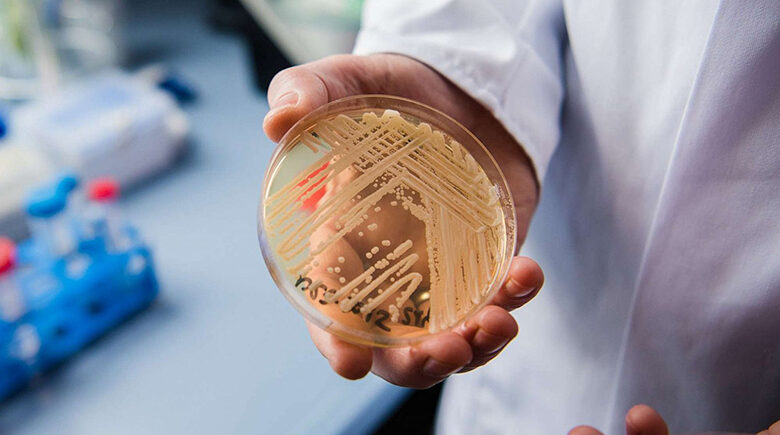

بكتيريا نادرة تثير الذعر في اليابان
بعد أن خُففت القيود المفروضة في عهد فيروس كورونا، انتشر في اليابان مرض ناجم عن “بكتيريا آكلة للحم” نادرة ويمكن أن تقتل الإنسان في غضون 48 ساعة.
فقد وصلت حالات متلازمة الصدمة السامة للمكورات العقدية المسماة “STSS” إلى 977 حالة هذا العام بحلول الثاني من حزيران الجاري.
وهو أعلى من الرقم القياسي البالغ 941 حالة تم الإبلاغ عنها طوال العام الماضي، وفقاً للمعهد الوطني للأمراض المعدية، الذي يتتبع حالات المرض منذ عام 1999.
فيما تسبب المكورات العقدية من المجموعة أ (GAS) عادةً تورماً والتهاباً في الحلق لدى الأطفال يُعرف باسم “التهاب الحلق العقدي”.
لكن بعض أنواع البكتيريا يمكن أن تؤدي إلى تطور الأعراض بسرعة، بما في ذلك ألم الأطراف وتورمها والحمى وانخفاض ضغط الدم، والتي يمكن اتباعها عن طريق النخر ومشاكل التنفس وفشل الأعضاء والموت.
أمَّا الأشخاص الذين تزيد أعمارهم عن 50 عاماً هم الأكثر عرضة للإصابة بالمرض.
بدوره أوضح كين كيكوتشي، أستاذ الأمراض المعدية في جامعة طوكيو الطبية النسائية أن “معظم الوفيات تحدث خلال 48 ساعة”.
وتابع قائلاً “بمجرد أن يلاحظ المريض تورماً في قدمه في الصباح، يمكن أن يمتد إلى الركبة بحلول الظهر، ويمكن أن يموت في غضون 48 ساعة”.
كما أضاف أنه “بالمعدل الحالي للإصابات، قد يصل عدد الحالات في اليابان إلى 2500 حالة هذا العام، مع معدل وفيات مرعب يصل إلى 30%”.
وحضّ كيكوتشي الناس للحفاظ على نظافة الأيدي ومعالجة أية جروح مفتوحة.



